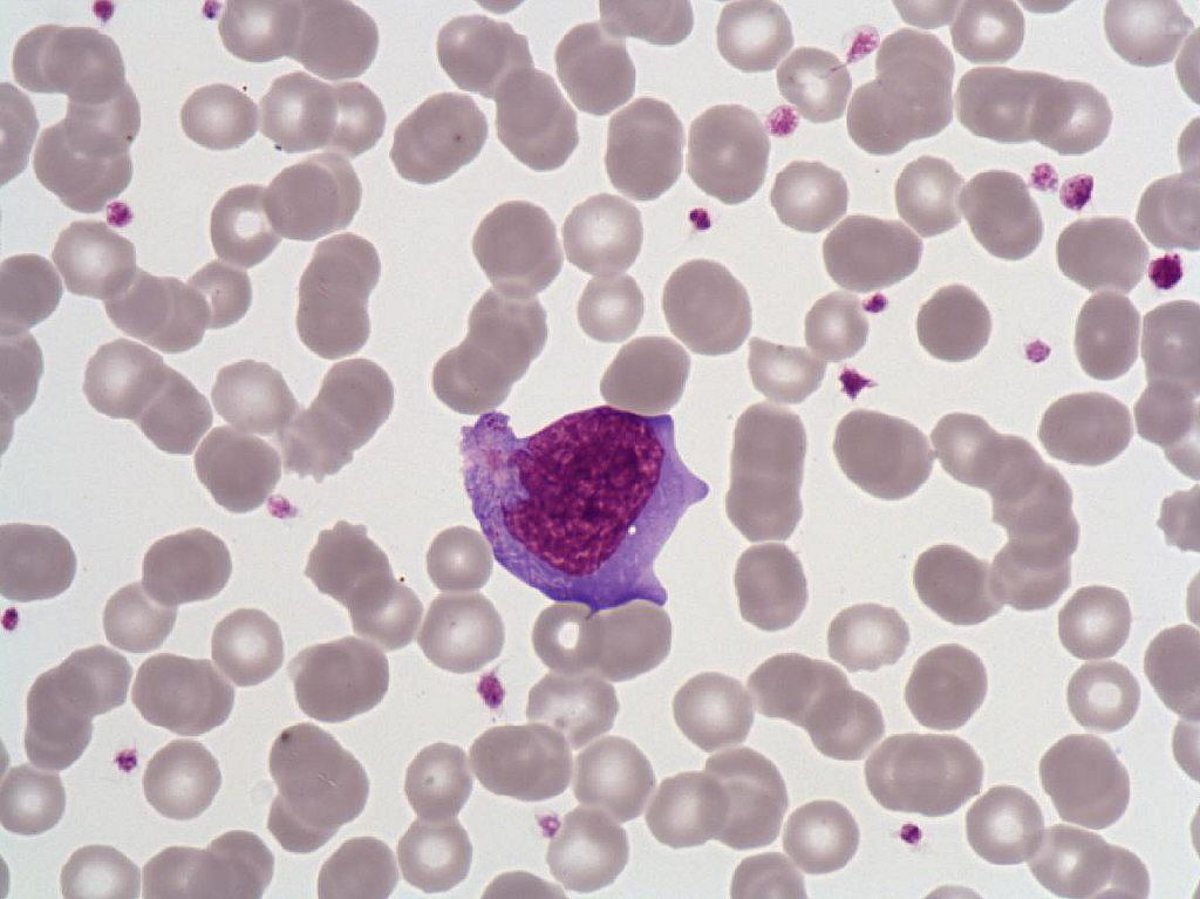
Hyperbasophilic_lymphocyte Hyperbasophilic_lymphocyte

Medium size cells, polymorphic, nucleus with condensed chromatin (rare presence of nucleolus in largest cells) intense homogenously basophilic extended cytoplasm or basophilic peripheral border.
Reactive lymphocyte. In mononucleosis syndrome (IM, CMV, toxoplasmosis, HIV primary infection, drugs) presence of more than 50% of total lymphocytes with> 10% hyperbasophilic lymphocytes, few rare plasma cells.